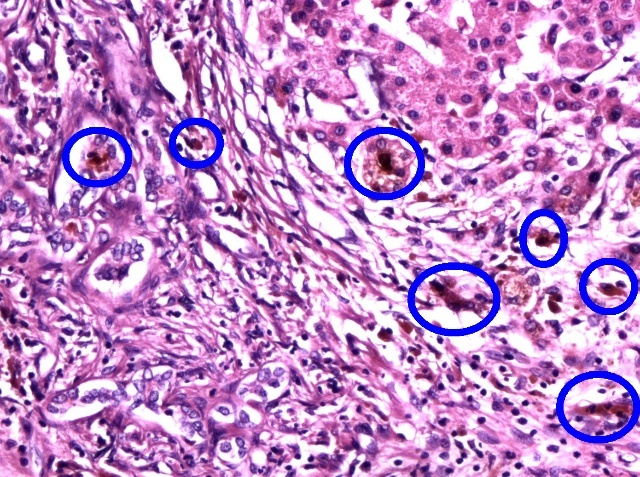

一. 人体有个大大的肝
肝脏的位置:
身体位于右上腹部,隐藏在肋骨的后面。当这个部位感到不适、疼痛时要想到肝脏。当受到外力的撞击时,也是需要重点保护的位置。

图1 肝脏在身体里的位置、大小、形状
肝脏的特点:
肝脏是身体里面最大的一个实质性的器官(反之,胃肠、肺等是属于中间有空腔的器官)。一般有三斤重(1.5公斤)。为什么肝脏要有那么大的体积和那么大的重量呢?其实,是由肝脏在身体里承担的重要作用决定的,因为,肝脏是人体功能最多的器官。目前已经知道的主要功能有6大部分:
1. 制造和分泌胆汁:肝脏将每天衰老的红细胞里的血红蛋白中的血红素转变成胆红素,并分泌到胆汁中,每日约有600-1000ml的胆汁从肝脏持续分泌出来,由胆管流入十二指肠,帮助脂肪消化以及脂溶性维生素A、D、E、K的吸收。一旦胆红素不能在肝脏正常产生和排出,就会堆积在血液里,于是,身体的皮肤就会出现黄颜色,这就叫“黄疸”。
2. 是代谢功能。我们每天吃进大量食物,食物中的蛋白质、脂肪、糖类以及维生素,必须先到肝脏进行化学处理,变成人体需要的养分,再供 生命活动所需。如果没有肝脏的辛劳,人体内的几百个大大小小的器官就会“饿死”。有关的代谢可以看到8个方面:
(一) 肝脏与糖代谢:平常所吃的米、面粉等多糖,在胃肠道被淀粉酶分解成单糖(即葡萄糖),经肠粘膜吸收。葡萄糖通过肝脏门静脉进入肝脏时,血糖升高,这时肝细胞合成肝糖原而被贮存起来。当人体饥饿血糖降低时,肝脏又把合成贮存糖原分解为葡萄糖,释放入血液,以供全身利用,糖产生热量。故肝脏有调节血糖的作用。岂不知,要想解决糖尿病,还得从肝脏入手呢。
(二) 肝脏与蛋白质的代谢:人们吃瘦肉,蛋类等蛋白质食物,在胃肠道内经过蛋白酶的作用。把食入的各种蛋白质分解为氨基酸。因为蛋白质是许多氨基酸通过肽链连接而成的物质。因此,氨基酸是组成蛋白质的最小单位。氨基酸分子小,能通过胃肠道粘膜吸收入血液,进入肝脏。肝细胞能把氨基酸重新合成人体需要的各种蛋白质、酶类等,如体内的白蛋白、凝血酶原等。肝脏有很强的蛋白质合成能力,除了免疫球蛋白外,几乎所有血浆蛋白都由肝脏制造。只要肝脏没毛病,任何蛋白质类的所谓“补品、营养品”都是多余的。
(三) 肝脏与脂肪的代谢:肝脏吸收脂肪分解为脂肪酸和甘油,再重新合成人体需要的脂肪而贮存在脂肪组织里。当人体饥饿或患糖尿病,血糖从尿中大量丢失时(糖丢失不能产生供机体需要的热量时),机体就会动员体内贮存的脂肪进行氧化,产生热量,以供人体热量的需要。肝脏是合成体内胆固醇的重要器官,血浆内的胆固醇约60%-80%,来自肝脏合成。要想降低血脂,首先要保证肝脏正常。
(四) 肝脏与胆红素代谢:胆红素在肝内的代谢过程包括肝细胞对血液内胆红素的摄取,结合胆红素的形成,结合胆红素从肝细胞排入胆道三个互相衔接的过程,其中任何一个过程发生障碍都可使胆红素聚积于血液内而出现黄疸。
(五) 肝脏与激素代谢:人体内性激,包括雌性、男性激素和肾上脉皮质类固醇激素转运于肝脏后即被摄取,经氧化还原,结合从胆道排泄,又经肠—肝循环最终从尿、粪排出体外。那么多“内分泌紊乱”的毛病,其实,根子在肝脏。
(六)肝脏与胶原代谢:胶原一般分成五型,被装配成胶原纤维,肝纤维化即肝组织内胶原堆积所致。弹力蛋白为弹力纤维的主要成份,它随I型胶原的增加而增加。基质是不定形粘液样凝胶状物,以蛋白多糖的形式存在。成纤维细胞参与肝结缔组成的合成与降解。肝硬化的实质还是在肝脏功能正常与否。
(七)维生素代谢:肝脏可贮存脂溶性维生素,人体95%的维生素A都贮存在肝内,肝脏是维生素C、D、E、K、B1、B6、B12、烟酸、叶酸等多种维生素贮存和代谢的场所。肝脏有毛病时一定要服维生素来补充的。
(八)热量的产生、水、电解质平衡的调节,都有肝脏参与。安静时机体的热量主要同身体内脏器提供。在劳动和运动时产生热的主要器官是肌肉。在各种内脏中,肝脏是体内代谢旺盛的器官,安静时,肝脏血流温度比主动脉高0.4-0.8℃,说明其产热较大。肝脏如同体内的小暖炉呢。
3. 是解毒功能。肝脏解毒主要有四种方式:⑴化学方法:如氧化、还原、分解、结合和脱氧作用;⑵分泌作用:一些重金属如汞,以及来自肠道的细菌,可随胆汁分泌排出;⑶蓄积作用;⑷吞噬作用。肝脏是人体的主要解毒器官,它可保护机体免受损害,使毒物成为无毒的或溶解度大的物质,随胆汁或尿排出体外。这是维持生命的重要功能。不管是食物、药物,都不可避免带有“毒性”,一旦肝脏解毒能力下降,后果不堪设想。
4. 吞噬或免疫功能。肝脏是人体内最大的防御系统,拥有一支强大的“健康卫士”队伍,通过吞噬、隔离和消除入侵和内生的种种致病原,从而保 障健康。肝功能不好的人之所以易与多种疾病结缘,奥妙就在这里。此外,还有胆汁生成和排泄,凝结血液以及调节水盐代谢等生理作用。总之,生命离不开肝脏,肝健康则生命昌盛。肝脏通过网状内皮系统的Kupffer细胞的吞噬作用,将细菌、色素和其它碎屑从血液中除去。任何免疫能力的维持与提高,都必需靠正常的肝脏功能。
5. 凝血功能
如果你刮胡须或削苹果时不慎弄伤皮肤,肝脏就会制造血凝块,使伤口停止流血。 肝脏是合成或产生许多凝血物质的场所。除上述的纤维蛋白原、凝血酶原的合成外,还产生凝血因子5、7、8、9、10、11和12。另外,储存在肝脏的维生素K对凝血酶原和凝血因子7、9、10的合成是不可缺少的。可想而知,肝脏有毛病后,血液不能凝固,会是什么后果。这也是为什么肝脏毛病的患者,后期任何医学救治都不能进行的原因所在(医生害怕出血不止而不敢采取任何措施了)。
6. 调节血液循环量:正常时肝内静脉窦可以贮存一定量的血液,在机体失血时,从肝内静脉窦排出较多的血液,以补偿周围循环血量的不足。所以,肝脏还是人体的一个小血库。
二. 肝移植已经成为终末期肝病的最佳选择
从20世纪90年代开始,国际上肝移植进展迅速,效果与日俱增,其已成为先进国家中许多大医院的常规手术。在亚洲,日本、我国台湾与香港地区相继开展,也取得良好成绩,国内外科医生们也随之跃跃欲试。尤其是新一代中青年医师,有的从国外学习肝移植回国,有的在国内作研究生或课题研究从事肝移植实验,均积累了一些经验,他们中不乏有事业心者,如果单位领导重视,给予物质和经费上的支持,这就具备了开展肝移植的主要条件。进入本世纪后的短短10多年中,肝移植快速发展,至今已经超过2万例。
近几年肝移植发展的主要原因:1、适应症改变:早期多为中晚期肝癌,现良性终末期肝病、先天性和代谢性疾病逐渐增多。2、技术趋于成熟,经验不断积累。3、根据不同患者、病情以及条件,开展了各种新的术式,如活体亲属部分肝移植、减体积式肝移植、劈裂式肝移植以及原位辅助性肝移植等。4、新保存液的应用。5、新一代免疫抑制剂的应用。6、学术交流和技术协作的增加。
这样一来,肝移植成为晚期肝病的最后一道防线,也可以说是各种肝脏疾病发展到终末期的惟一根治手段。从目前的情况来看,肝脏移植已适用于60多种疾病。主要包括肝脏实质性疾病、先天性代谢障碍性疾病、胆汁淤积性疾病、肝脏肿瘤等。尤其是逐步发现,儿童接受活体亲属供肝行肝移植治疗目前尚无法治疗的一些肝衰竭,可以取得理想的效果。
三. 肝的再生能力出乎人们的意料
由于B超、CT等检查手段的出现,人们对于肝脏小、形状、结构的认识一下子方便起来了。于是好奇的问题出来了:对于一个人的肝切除一半后剩下的一半肝以后会怎么样?真可谓不看不知道,一看吓一跳!3个月后,原本只有一半的肝脏几乎变成了一个完整的肝脏!这就是说,几个月的时间,肝脏增加了一倍。
肝脏之所以再生,是因为肝细胞再生能力极强。肝脏是由肝细胞组成,肝细胞极小,肉眼看不到,必须通过显微镜才能看到。人肝约有2000亿个肝细胞,组成约有50万个肝小叶,由肝小叶组成左右两半(右叶占全肝的60%),分为五叶(左叶、左旁中叶、尾叶、右旁中叶、右叶)和八段。
正常人肝细胞没有表现出旺盛的再生能力,但在肝受损后,尤其是肝部分切除后,肝细胞有惊人的快速增殖能力。动物实验证明,当肝脏被切除70-80%后,并不显示出明显的生理紊乱。而且残余的肝脏可在3-8周内长到原来大小。这说明,肝脏具有再生功能。人体切除二分之一后,不到半年就可以又长出那半个肝脏出来。这就是现在为什么亲属间互相可以供给一半肝脏进行移植了。

图2 正常人的肝脏是由肝细胞组成的肝小叶构成的

图3 圈中可见两个再生的肝细胞
当肝脏受物理化学因素损伤或部分切除时,肝实质细胞能迅速反应。肝小叶各部位肝细胞增殖反应速度不同。进来研究发现,骨髓细胞可以到肝脏分化成肝细胞,这样就为肝细胞再生提供了新的途径。
四. 肝脏是公认的免疫耐受特惠器官
人类进化的亿万年中,机体巧妙地形成了一整套自我保护的机制,即任何“外来者”都不可能在自己体内生存,都会被“消灭”,这就叫移植排斥。所谓“移植”就是用正常的细胞、组织或器官替换受损伤或失去功能的组织或器官的方法。
移植的组织或器官称移植物(graft),提供移植物的个体,称供者(donor)。接受移植物的个体,称受者(recipient)。
古代人就曾幻想过器官的移植,但直到上世纪50年代才有了人体真正的器官移植。迄今,全世界的器官移植数已达到100多万例次。而且人的各种重要器官,如心、肝、肺、脾、肾、胰、骨髓等都可以移植。奇怪的是在这众多器官的移植中人们发现,肝移植有别于其它器官移植的一个显著特点是几乎不发生超急性排斥反应(Hyperacute rejection, HAR),急性细胞排斥(Acute cellular rejection, ACR)较易控制,甚至慢性排斥也可得到纠正,总之,反应程度都轻。因此,目前肝脏是公认的免疫耐受特惠器官,移植前供着与受者仅需对ABO血型相配即可,而对其它器官移植必需的HLA配型并不严格。这一现象不得不引起研究者的兴趣。其确切机理目前尚不清楚,可能有关的一些因素是:
1. 肝脏是一个没存神经的“沉默器官”。 事实上,肝脏中不存在末梢神经,因此肝脏即使发生病变,一般没有痛感,不像胃、肠、心脏等器官那样-旦受损便会剧烈疼痛。因此,肝脏在无神经环境中对于机体的识别应该有所“逃逸”。
2. 肝细胞中包含2000种以上的生物酶,作为人体化学反应的媒介,参与人体各类生命活动,肝脏之所以被称为“人体的综合化工厂”。这2000种以上的酶在“帮助”肝脏“消除”着识别与排斥上应该起着一定的作用。
3. 供体的肝细胞分泌可溶性HLA I型抗原,它可能有免疫抑制功能。
4. 肝脏内有强力的“清除”细胞,它们吞噬补体、免疫复合物和抑制血小板凝聚而免除排斥反应的产生。
5. 肝脏独特的双重血供系统等。
相信随着研究的一步步深入,谜团会越来越少的。
五. 先天性胆道闭锁是亲属供肝行肝移植的理想途径
先天性胆道闭锁(congenital biliary atresia)是新生儿长期阻塞性黄疸的主要原因。
是一种肝内外胆管出现阻塞并可导致淤胆性肝硬化而最终发生肝功能衰竭的,平均生存期为12个月。也就是说,一旦发现,只能存活1年时间。
患儿一般在出生后1-2周时会出现眼睛、全身皮肤的黄染,并不断加重,同时大便出现黄白色、陶土色,尿色随黄疸加重而加深,尿布可染黄,渐渐食欲不振,营养不良,肝大、脾大、腹部膨隆。随着病情发展,最终会发生胆汁性肝硬化和门静脉高压症,出现鼻衄,皮肤黏膜瘀斑,食管静脉曲张引起的消化道出血,肝昏迷,肝功能衰竭而死亡。更主要的是没有治疗的好办法。很多患儿家长试用过很多药物,包括中药,基本都是无效的。因此,肝移植成为唯一有效治疗手段。

图4 切下来看到患儿已经硬化了的肝脏

图5 硬化肝脏切开来看到的样子

图6 硬化肝脏显微镜下的表现(与图2比较看就明显不同了)
图7 圈内示黄褐色的胆汁淤积
这种病的肝移植是患儿父母或直系亲属捐出一小部分肝脏给患儿,通常是捐出整个肝脏的15%-20%便可以满足患儿的需要。因为人体肝脏有强大的再生功能,因此捐肝者不用担心自己肝脏和身体会不会受到影响。同时捐出的肝脏,在患儿体内也会随着患儿的生长发育而生长。
亲属供肝行肝移植的优势:1)救活了一个年幼的生命;2)提供者自己没有今后身体的担心;3)术前可以对供体行CT、MRI等各项检查,从而有助于按最佳比例选取容量,使移植肝与受体更为匹配,术前亦可通过各项检查了解血管等解剖因素,有利于血管重建;4)可依据ABO 血型、白细胞抗原及HLA的分析结果,获得更适宜的供受体组织相容性配型;5)有助于取得家庭心理效应,家庭更加融合在一起。
总之,为了孩子的肝脏,大张旗鼓开展亲属间的肝移植吧!


